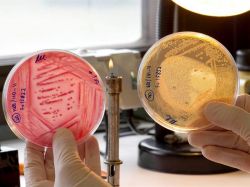
Gobierno de Perú toma medidas para prevenir la E.coli

Gobierno de Perú toma medidas para prevenir la E.coli
Las personas que arriben a Perú con síntomas relacionados con una infección de E.Coli, la bacteria que ya ha dejado 35 fallecidos en Europa, serán aislados y evaluados, informó hoy el ministro peruano de Salud, Oscar Ugarte.
Ugarte señaló que esta medida hace parte del plan de prevención lanzado por el Gobierno peruano para evitar el ingreso de la bacteria al país.
"Las precauciones que debemos tener se orientan a que estos casos no lleguen al país, y si llegan, que sean detectados rápidamente. Una persona con solo unas horas en Europa puede venir contaminado y si presenta un cuadro diarreico debe ser aislado", afirmó Ugarte a la agencia estatal Andina.
Según explicó el ministro, algunas personas con enfermedades gastrointestinales pueden presentar especial resistencia ante el bacilo de E.Coli, por lo que cualquier visitante al país que presente esos desarreglos intestinales debe ser evaluada por especialistas.
"La bacteria en Alemania es una variedad que ha mutado y es más agresiva. Por ello se recomienda a las personas que llegan al país con esta sintomatología, acudan a un centro de salud", agregó Ugarte.
La variante agresiva de la E.Coli ha causado la muerte a 34 personas en Alemania y una más en Suecia.
La medida adoptada por el Gobierno peruano se suma a otras similares en otros países de la región latinoamericana, como la iniciada por Colombia el pasado jueves y que consiste en la realización de acciones inspección, vigilancia y control en puertos marítimos y aeropuertos a viajeros y mercancías.
Por otro lado, el titular de la cartera de Sanidad informó de que en la última reunión iberoamericana de ministros de Salud se acordó efectuar una venta conjunta de medicamentos, con el objetivo de abaratar costes.
Ugarte detalló que el proceso de compra concluirá en agosto y por parte del Perú implicará la compra de medicinas prioritarias, como las oncológicas, antirretrovirales y antimaláricas.
Fuente y Foto: EFE